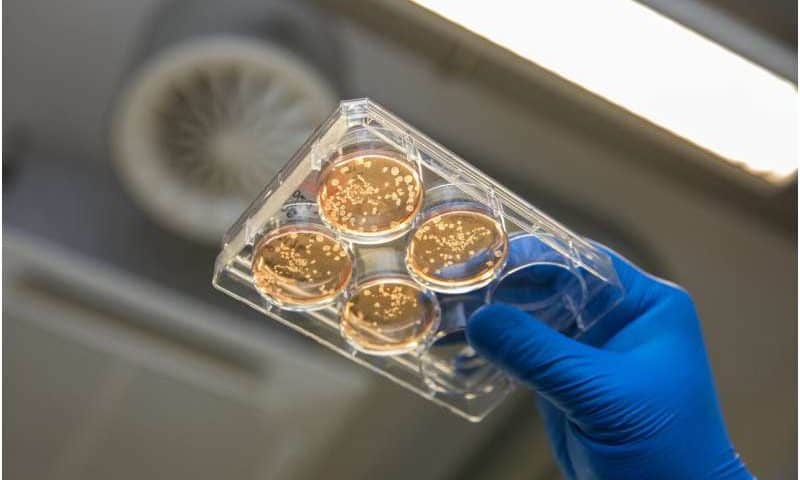
New bioreactor turns stem cells into an immune-cell factory, producing 40 million human macrophages per week

Researchers at Hannover Medical School (MHH) have developed a method for the efficient production of human immune cells, such as macrophages, in medium-sized bioreactors. These immune cells can be derived from induced pluripotent stem cells and are important for disease research and the development of new therapeutic approaches. The method has now been published in the journal Nature Protocols.
Macrophages—also known as “scavenger cells”—play a central role in the human immune system. They are indispensable for defending against pathogens and for repairing damaged tissue. Furthermore, they are already being used in clinical therapy, for example in the treatment of liver diseases. Scientists are also investigating further potential applications—including for the treatment of infectious diseases, inflammation, fibrosis and cancer, as well as neurodegenerative diseases such as Alzheimer’s. Macrophages are also suitable for testing drugs for purity, safety and efficacy.
Efficient, cost-effective and easy to use: The new bioreactors
For research purposes, macrophages can be produced from so-called induced pluripotent stem cells (iPS cells). These are somatic cells that have been “reprogrammed” using biotechnology and from which, in principle, any type of cell in the body can develop. Until now, macrophages have mostly been produced either on a small scale for laboratory studies or on a large scale for industrial applications. Medium-sized bioreactors, which are particularly well suited to preclinical research projects because they are efficient, cost-effective and easy to handle, have been virtually non-existent until now.
A team led by Prof. Dr. Nico Lachmann from the Department of Pediatric Pneumology, Allergology and Neonatology at Hannover Medical School (MHH) has now developed a technique for creating such bioreactors.
A valuable tool for science
Using the new method, iPS cells continue to differentiate in a culture medium and form cell aggregates, known as organoids, within 14 days. These structures, which resemble hematopoietic bone marrow, subsequently release macrophages on a continuous basis. “We can harvest up to 40 million immune cells per bioreactor every week over a period of 10 weeks,” says Professor Lachmann.
Four bioreactors are combined in a single device. The technology thus offers a valuable tool for research into human immune cells and their medical applications.